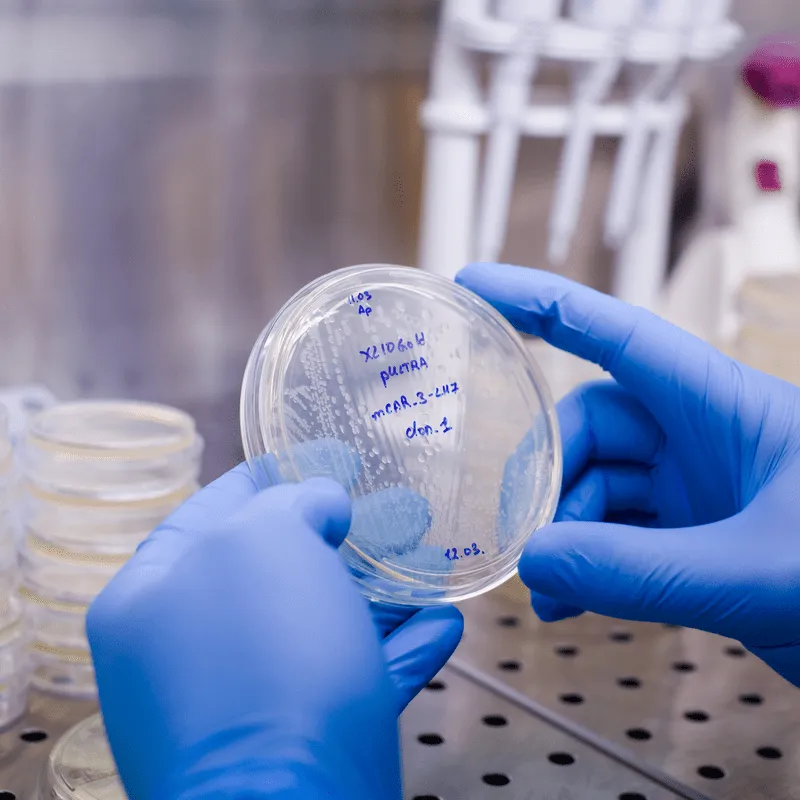
Getting to Know the Abecma (ide-cel) CAR T Therapy image

Getting to Know the Abecma (ide-cel) CAR T Therapy

Event Description
Everyone has been hearing about the newly FDA-approved Abecma (ide-cel) CAR T therapy, but what is this treatment? Who qualifies for it? And how can you sign up? Hear from multiple myeloma specialist Dr. Nina Shah as she shares the practical side of the CAR T and answers your questions.
Schedule & Agenda
Speakers & Moderators

Myeloma survivor, patient advocate, wife, mom of 6. Believer that patients can help accelerate a cure by weighing in and participating in clinical research. Founder of the HealthTree Foundation.

Audrey joined the HealthTree Foundation as the Myeloma Community Program Director in 2020. While not knowing much about myeloma at the start, she has since worked hard to educate herself, empathize and learn from others' experiences. She loves this job. Audrey is passionate about serving others, loves learning, and enjoys a nice mug of hot chocolate no matter the weather.
Dr. Nina Shah is a specialist in blood diseases who focuses on treating multiple myeloma, a type of cancer affecting certain cells in the bone marrow. Her areas of professional interest include the intersection of immunology and oncology as well as helping patients fight multiple myeloma by boosting their immune systems. Shah earned a bachelor's degree in cognitive neuroscience at Harvard University, followed by a medical degree from New York University School of Medicine. She completed a residency in internal medicine at Columbia University and a fellowship in hematology-oncology at the University of Texas MD Anderson Cancer Center. Shah belongs to the American Society of Clinical Oncology, American Society of Hematology and American Society for Transplantation and Cellular Therapy. She speaks Bengali and Spanish.
Join the Conversation
This event is part of the Disease Progression and Relapsed/Refractory group in HealthTree Connect, a social media platform for people with blood cancer. If you want to connect with other patients and caregivers and talk about this topic, join HealthTree Connect.
Have Any Questions?
Thank you for your interest in the event. If you have any questions, we would love to help!
Feel free to give us a call or send us a message below.

Get In Touch With Us
1-800-709-1113
Support@healthtree.org
Get the Latest Multiple Myeloma Updates, Delivered to You.
By subscribing to the HealthTree newsletter, you'll receive the latest research, treatment updates, and expert insights to help you navigate your health.
Together we care.
Together we cure.